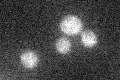

View description
Predicted membrane protein required for the retention of lumenal endoplasmic reticulum proteins; mutants secrete the endogenous ER protein, BiP (Kar2p)
Localization:
Intensity:
Fold change:
Significance:
-
C’ GFP library in SD
below threshold16.97 -
N' NOP1pr-GFP in SD

N/A0 -
N' TEF2pr-mCherry in SD

N/A0 -
N' NATIVEpr-GFP in SD

N/A0 -
N' TEF2pr-VC and Cyto-VN in SD

N/A0 -
C’ GFP library in SD+DTT

ambiguous15.70.92No -
C’ GFP library in SD+H2O2

ambiguous17.11No -
C’ GFP library in Starvation Media

ambiguous17.331.02No -
C’ GFP library on the background of Pup2-DaMP

below threshold -
C’ GFP library on the background of CCT mutant

below threshold16.12320.949594No
